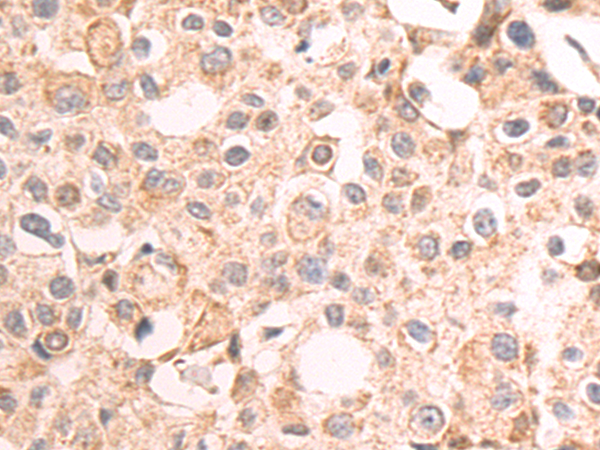
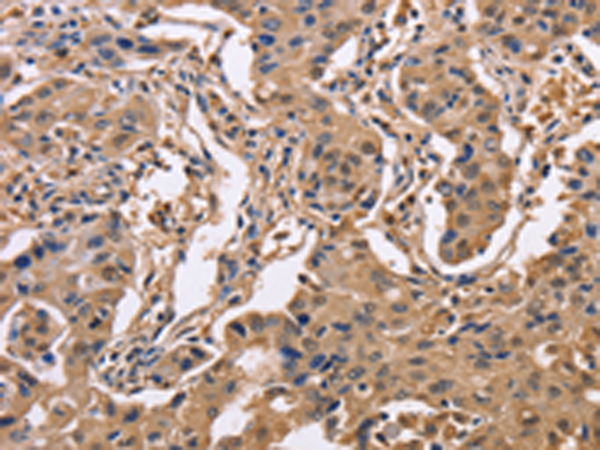

-
分类: 科研抗体货号: P07954别名: MAY1; PKCD; nPKC-delta应用: WB,IHC反应种属: Human, Mouse, Rat
-
分类: 科研抗体货号: P07952别名: BARK2; ADRBK2应用: IHC反应种属: Human, Rat
-
分类: 科研抗体货号: P07970别名: IDH; IDP; IDCD; IDPC; PICD应用: WB,IHC反应种属: Human, Mouse, Rat
-
分类: 科研抗体货号: P07951别名: RS; RGS; ARP1; Brx1; IDG2; IGDS; IHG2; PTX2; RIEG; IGDS2; IRID2; Otlx2; RIEG1应用: WB反应种属: Human, Rat
-
分类: 科研抗体货号: P07986别名: HK; HKD; HKI; HXK1; RP79; HMSNR; HK1-ta; HK1-tb; HK1-tc; hexokinase; HKII; HXK2应用: WB,IHC反应种属: Human, Mouse, Rat
-
分类: 科研抗体货号: P07969别名:应用: IHC反应种属: Human, Mouse
-
分类: 科研抗体货号: P07978别名:应用: WB,IHC反应种属: Human
-
分类: 科研抗体货号: P07985别名: HXK3; HKIII应用: IHC反应种属: Human, Mouse, Rat
-
分类: 科研抗体货号: P07968别名:应用: IHC反应种属: Human, Mouse, Rat
-
分类: 科研抗体货号: P07977别名: LZK; MLK; MEKK13应用: IHC反应种属: Human, Mouse

鄂公网安备42018502007531号
鄂公网安备42018502007531号

